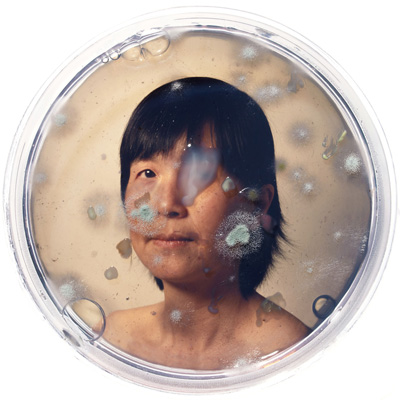

SEASON 11
EXHIBITS IN THE GALLERY
September 2014 - August 2015
| ORDER the 340 page season-documenting hardcover Manifest Exhibition Annual (MEA s11). |
 |
| September 26 - October 24, 2014 | SEASON OPENER Opening Friday September 26, 6-9 p.m. |
main gallery + drawing room
NEITHER HERE NOR THERE Sponsored by FOTOFOCUS
Over its ten seasons of non-profit programming Manifest's competitive projects have attracted submissions by artists from 89 countries and all 50 U.S. states. In honor of this global vitality focused from there to here (from the world to our humble spot in Cincinnati, Ohio) we offered Neither Here Nor There as a competitive invitation for artists near and far to reveal aspects of location in their photographic and lens-based works of visual art. Works on view represent location by virtue of their creation in a particular place, regardless of subject matter. With some playfulness the theme may be further interpreted based on the typical meaning of "neither here nor there" as in "of little or no importance." So works that represent ordinary, everyday things, events, or places will add yet another layer to the resulting exhibition. One can also interpret the theme by focusing on the concept of "in-between" (e.g. transitions, empty spaces, half-states, and so on.) Manifest's ten-member jury (comprised mostly of professional photographers) reviewed 606 works by 181 artists from 35 states, Washington D.C., and 10 countries. Nineteen works by the following 17 artists from 8 states and 4 countries were selected for exhibition and will also be featured in the Manifest Exhibition Annual publication (MEA) at the close of the season. The $1,000 Best of Show prize was awarded to Gloria Houng for her work entitled "Standard Double (Feet)".
Presenting works by: Nicholas Arbatsky Patty Carroll Emma Charles Spencer Cunningham Steven Elbert Bryan Florentin Peiter Griga Gloria Houng Austin Irving Daniel King Kent Krugh Armin Mersmann John Roberts Julia Romano Edward L. Rubin Jiehao Su Kathleen Taylor
|
Gloria Houng
Kent Krugh
Edward L. Rubin
Kathleen Taylor
|
parallel space
FRAME WORK
This solo exhibition of ten of Lars Anderson's photographs is one of eleven selected from among 199 proposals submitted for consideration for Manifest's new season. Anderson's work reveals the sublime opportunities lying dormant all around us. With a keen eye and deeply sensitive artist's mind his perception, viewfinder-framing, and shutter releases create intricate abstractions—objects of zen-like truth and contemplation many painters only dream of achieving. This revelation of simple, ordinary, yet hidden beauty echoes perfectly the theme of the concurrent exhibit "Neither Here Nor There". This brings a delightful unity to the suite of exhibitions on view to launch Manifest's 11th season. Anderson will discuss his work, intriguing background, and creative ideas at a free public gallery talk on Saturday, October 11 at 5pm. Of his work Anderson states: "I have been fascinated by the industrial world since childhood. I believe this deep and abiding interest comes from an appreciation for things that are solid, precise, and useful. When I became an artist, I began to enjoy the less utilitarian, more aesthetic aspects of that world. Lines, shapes, forms and colors make industrial reality. Simultaneously, they create abstractions that are interesting and sometimes sublime. This body of work seeks balance. While it’s possible to remove some of the visual cues that anchor these images in the real world and make them purely non-representational, I prefer to observe how abstract elements combine to form the things we see. I believe there is value in looking at the world more closely. This work describes how we can find beauty in unexpected places if we look again, reconsider, or simply stand in a different place.” Lars Anderson was born and raised in Iowa. As a child, he sketched imaginary industrial landscapes and drafted architectural plans for buildings that would never exist. He moved to Cincinnati, Ohio in 2006 and began photographing the industrial realms of the Ohio and Mississippi river valleys in 2007. His current work focuses on the unexpected beauty found in both abandoned and active manufacturing sites. His work has been included in various group shows and an award-winning publication, and has been the subject of several solo shows.
|
|
central gallery
DRIVE THRU
This solo exhibition of a looping suite of Leigh Merrill's video assemblages is one of eleven selected from among 199 proposals submitted for consideration for Manifest's new season. Merrill's work brings the element of time into a predominantly frozen suite of photographic exhibitions. Yet her subtle digital assemblage technique mirrors that of fellow exhibitors Dominic Lippillo and Mark Schoon (Conflation). Merrill's interest in places links perfectly with Neither Here Nor There, adding a wonderful irony to that theme by virtue of her believable yet completely invented locations (truly neither here nor there!) Presented in the Central Gallery with the videos projected wall-size, Merrill's exhibit is bracketed by those of Lars Anderson and Lippillo & Schoon, and therefore serves as a conductor between those exhibitions. This mixture will provide visitors to the gallery an experience of the subtlety of photography and a deeper view into the concept of location.
Of her work Merrill states: "My work explores the places that surround us, spaces that often overflow with contradictory architectural styles and cultures – the voices of different eras – all struggling for visual prominence. I make thousands of individual photographs, videos and audio recordings while exploring a city or neighborhood. In the studio, I then digitally assemble and re-assemble these sources to create new photographs and videos of imaginary spaces. Each image is typically made from tens to hundreds of bits and pieces of different photographs or videos. Some of the images have some veracity, but more often they suggest a visual hyperbole – an embellished scene circulating around a small detail or object that fascinated me. The scenes in both the photographs and the videos are spaces that feel familiar but not place-able. They tap into some of the conscious and subconscious visual cues, barriers and borders we create – a language that is shared by urban, suburban and rural spaces. The movements in the videos are the subtle, ambient changes in an environment: leaves fluttering in the wind, the movement of clouds, light and shadows shifting on the street. The faint movement in these videos share as much with photographs as moving images: the vantage point is fixed and the stillness of the scene is amplified by the faint changes in each environment. The imagery in both the videos and photographs play off one another creating a sense of pleasure and curiosity in seeing the familiar become unfamiliar.”
Leigh Merrill received her BFA from the University of New Mexico and her MFA from Mills College. Her work has been a part of exhibitions throughout the United States in venues such as the Phoenix Art Museum, the diRosa Art Preserve, The Lawndale Art Center, the Tremaine Gallery, and the Museum of Texas Tech University. Merrill’s work has been included in online and print publications such as the Design Observer/Places Journal, Dwell.com, BLDGBLOG blog, PaperCity Magazine, and the Houston Chronicle. Her work is part of the permanent collections of the Museum of Texas Tech University, the City of Phoenix, the California Institute of Integral Studies and various private collections. Merrill currently lives and works in Dallas, Texas where she is an Assistant Professor of Art at Texas A&M University-Commerce.
|
|
north gallery
CONFLATION
This exhibition of nine of Dominic Lippillo and Mark Schoon's collaborative photographs is one of eleven selected from among 199 proposals submitted for consideration for Manifest's new season. Lippillo and Schoon's exhibit of photographs caps off the gallery-by-gallery suite of four exhibitions created for the FotoFocus Biennial. Further exploring the notion of location, this time by way of a filter of dualistic viewpoints (left and right halves), the works tie up the thread started in Neither Here Nor There, focused and contemplated in Frame Work by Lars Anderson, and activated in Drive Thru by Leigh Merrill. Like Merrill's Drive Thru, Conflation provides a glimpse into places that are at once real (when considering the parts) and unreal (when taking in the whole). But here the assemblage represents yet another kind of location–that of the individual artists, the places they are, and the similarities and differences between the ways they see the world.
Of their work the artists state: "In 'Conflation' interior images of our homes are visually connected to create the illusion of a singular photograph and space. The literal connection of the images in the print creates a thin seam that appears and disappears. This newly forged space forms a photographically unique location where memories and past experiences merge to create new histories, narratives, and non-places. Through the language of photography we attempt to subvert geographic location while using the camera to deconstruct and explore time, space, distance, and visual perception.”
Dominic Lippillo and Mark Schoon earned their MFA’s in Photography from Ohio University in 2009. Working independently with lens-based media they soon realized they had a shared interest in the domestic. Although they approach their solo work differently, a common sensibility could be recognized in the earlier work of both artists leading to the creation of their first collaborative effort, Anti-local. Selections from their collaborations are included in the permanent collection of The Museum of Photographic Art; The Museum of Fine Arts, Houston; The University of Alabama, Tuscaloosa; the Journal Exposure, and in the supplement of images accompanying Bruce Warren’s textbook Photography: The Concise Guide (2nd Edition March 2011). Lippillo is an Assistant Professor of Art at Mississippi State University. Schoon is an Assistant Professor of Art at The University of West Georgia.
|
|
| November 7 - December 5 | Opening Reception Friday November 7, 6-9 p.m. |
main gallery + drawing room + parallel space
FACE FIRST
We consciously and unconsciously categorize identity based on the human face. It is, for most people, their social thumbprint and emotional signpost. Inevitably the face is the ‘I’ in first person statements. Manifest's seven-member jury reviewed 613 works by 215 artists from 41 states, Washington D.C., and 7 countries. Thirty-seven works by the following 31 artists from 17 states and 2 countries were selected for exhibition and will also be featured in the Manifest Exhibition Annual publication (MEA) at the close of the season.
Presenting works by: Jeffrey Abt Luis Alvarez Roure Jimmie Arroyo Debra Balchen Angela Cunningham Daniel Dallmann Hélène Delmaire Thomasin Dewhurst Yuxiang Dong Phil El Rassi Reed Govert Tanja Gant Mark Hanavan Willie Jones Ricki Klages Eileen MacArthur Louis Marinaro Omalix Martin O’Connor Miriam Omura Keith Parks Ann Piper Matthew Schenk Sohail Shehada Isaac Smith David Stanger Judy Takacs Derek Wilkinson Ben Willis Dennis Wojtkiewicz Caomin Xie
|
Yuxiang Dong
Reed Govert
Miriam Omura
Keith Parks
|
central gallery
EXTREMITIES
They're a part of us we take for granted, like everything else we've lived with all our lives from birth. Naturally they feel less just a part, and more an inseparable extension of our wholeness. Yet when lost, paralyzed, or wounded, our hands and feet are recognized for what they are–the outermost point of contact our minds have with the world outside our bodies. Anthropologically they define our specie, served its propagation around the globe in distant pre-history, and even provided the hand-stamp signature on our oldest surviving paintings from 40,000 years ago. The hand and the foot remain a powerful reminder of our humanity, our physicality, and our origins. Not solely practical tools for locomotion, survival, and the manipulation of our environment, they also carry our expression. We can speak fluently with our hands, punctuate vocal speech, and express love and tenderness with our touches, trust and agreement with a handshake, or great violence and anger with a simple gesture. One could claim that all we are, all we have accomplished in our time on Earth–both good and ill–is an expression of these extremities. Manifest's seven-member jury reviewed 334 works by 126 artists from 30 states and 8 countries. Nine works by the following 9 artists from 5 states were selected for exhibition and will also be featured in the Manifest Exhibition Annual publication (MEA) at the close of the season.
Presenting works by: Jamie Bates Slone Cynthia Gutierrez Jee Hwang Carrie Lingscheit Daniel Maidman Elena Peteva Hyeyoung Shin Rachel VanWylen Erica Young
|
Danial Maidman
Erica Young
Hyeyoung Shin
|
north gallery
LOSING YOUR HEAD
We vertebrates are really not all that different under the skin. The thing that cradles our concept of identity, and houses our intellectual and emotional organ–our command center if you will, the skull–has long been the subject of visual art. The articulation of our interest in the subject runs the gamut from cliché to horrific, from the ironic to the tragic, and all points between. Contemplating the human or animal skull is akin to contemplating a star-rich night sky. It can often serve as a talisman of self-reflection, of proof of mortality, endurance, and commonality. Our fascination with the skull goes far deeper than the common symbolism it is burdened by today, and broader than its past use in phrenology or to support theories regarding sexual dimorphism. Ultimately the skull is evidence, after all, that we are in fact made of dust. Manifest's seven-member jury reviewed 342 works by 131 artists from 32 states and 7 countries. Eleven works by the following 10 artists from 8 states were selected for exhibition and will also be featured in the Manifest Exhibition Annual publication (MEA) at the close of the season.
Presenting works by: Angela Cunningham David Dorsey Mitch Eckert Alia El-Bermani TyRuben Ellingson Marshall Harris Todd Kunkler Josh Raftery David Stanger Derek Wilkinson
|
Angela Cunningham
TyRuben Ellingson
Josh Raftery
|
| December 12, 2014 - January 9, 2015 | Opening Reception - Friday, December 12, 6-9 p.m. |
main gallery
5th Annual TAPPED
The relationship between art students and their professors can be a powerful one. Even when this bond is left unstated, we carry our professors' voices forward in time as we mature as artists and people. We eventually realize that the instruction given by our teachers during our relatively brief careers as students continues to expand within us. We realize that the learning they inspired (or insisted upon) is a chain-reaction process that develops across our lifetime. All of us who have been students carry forward our professors' legacy in one form or another. And those who are, or have been professors, bear witness to the potency of studenthood. Out of respect for this student-teacher bond, and in honor of professors working hard to help their students tap into a higher mind relative to art and life, we offer TAPPED, an annual exhibit that presents works of art by current or former professor/student pairs. For this exhibit 95 artists submitted 272 works for consideration. Sixteen works by the following 16 artists from seven states and Canada were selected for presentation in the gallery and Manifest Exhibition Annual publication. The artists are listed in pairings to illustrate their teacher/student relationship. Works on view will include several paintings along with a number of drawings, collages, prints, and photographs. The exhibition layout is planned so that each pair of artists' works will be shown side-by-side or in close proximity. Visitors will be able to enjoy the variety of types of works while also considering the nature of influence between professor and student.
|
|
drawing room
A Dozen Years of Interiors
This exhibit of Matt Klos's work provides a mini-retrospective of his investigations of interior space through painting. As we have often found in contemporary perceptual painting, Klos's works echo the sentiment that amongst the mundane, everyday stuff of our lives exists incredible opportunity for eloquence and contemplation. The ten works in this exhibition offer impecable painting, and imagery that anyone can relate to. The tranformation of the subjects into works of art through paint serves as a filter by which the ordinary becomes sacred. Klos will discuss his work, background, and ideas about painting at a free public gallery talk on Friday evening, January 9 at 6:30pm. Of his work Klos states: "These works chronicle a dozen years of paintings that depict my views of the city, the suburbs, and studio environments where I have made art. These interior paintings share qualities and yet each environment offered me different opportunities for investigation. The resultant paintings display both my personal creative vision and pictorial anecdotes that were born by enacting a creative process within a definitive space. The latter aspect of the creative process, those aspects of each environment that imprinted upon my creative work, is the impetus for this exhibit. Painting the interior continues to be my chief interest although I have painted landscapes and made constructions that diverge from perception in recent years. Interiors encapsulate many of my core interests in painting, namely complex lighting constructs, opportunity for a long duration of observation, geometric structure, a human element and implied narrative (mystery), varied color, conveying a mood, a modicum of control (not too much and not too little), a rich history, and the magical experience of looking with a discerning eye." Matt Klos is a painter of interiors and plein-air landscapes that have taken him to Stonington, Maine, New Brunswick, Canada, and the Brittany region of France. His works have been exhibited nationally and internationally and he was awarded Individual Artist Awards from the Maryland State Arts Council in 2008 and 2012. His work was selected for a solo exhibition award at the Prince Street Gallery in Chelsea, NY in 2011 and he received an Elizabeth Greenshields Foundation Grant in 2001. Klos teaches drawing and painting at Anne Arundel Community College and took a sabbatical in fall 2013 to work on two projects: to create paintings of dozens of dilapidated buildings at the Fort Howard Veteran's Facility in Edgemere, Maryland and to curate an exhibition entitled A Lineage of American Perceptual Painting, highlighting the works of the great American painter Edwin Dickinson and the subsequent generations of painters whom he influenced and inspired. The exhibition will be on view in spring 2015 at the Mitchell Art Gallery at St. John's College in Annapolis, Maryland. Klos received an MFA in painting from University of Maryland, College Park in 2004 and a BFA in fine arts from Columbus College of Art & Design in 2001. He currently lives in Baltimore, Maryland with his wife and three children.
Klos's work has been exhibited at Manifest in numerous group shows and is also included in Manifest's International Painting Annual 3 receiving third place award.
|
|
parallel space
REGIONAL SHOWCASE
In its first ten seasons Manifest's projects included works by artists in 50 states and 37 countries. Starting with its 10th season Manifest launched a new ongoing series of exhibits focusing on works by artists living in its own three-state region. Season 11 continues that series, and adds projects focusing on definable regions outside our own. Our Regional Showcases are intended to complement the ordinarily very wide geographical makeup of most Manifest exhibits with a closer look at what's being done here, now, in our own backyard. Manifest was founded, and continues to be operated by regional artists, so it is fitting that the organization should offer the Regional Showcase series. We feel this is important for the artists of our area and the public living within reasonable driving distance of the gallery. It will give each a chance to show and share, and to gain perspective on our region's creative wealth as it relates to the broader art world. For this fourth in the series, which will change in theme and scope from show to show, we opted to survey the region for works of painting. Manifest's several-member blind jury process reviewed 290 works by 102 artists in Ohio, Kentucky, and Indiana. Seven works by the following 7 artists from Ohio and Indiana were selected for exhibition and will also be featured in the Manifest Exhibition Annual publication (MEA) at the close of the season. Of particular importance in this exhibition is the fact that, due to its nature and the proximity of entrants to Manifest, our jurors were deliberately selected from four states outside the OH, KY, & IN tristate, as well as from one European country in order to maintain a purely objective, outside judgment of the works submitted. This having been done, the jury resulted in both current Manifest Artists in Residence* having works included in the exhibit. We are proud of the fact that this process served as an independent verification that Manifest is attracting some of the very best artists in the region to its programs, and supporting them in further pursuit of excellence. Presenting works by: Damon Mohl CK Nichelson Steve Paddack Nathan Perry Jesse Thomas Christina Weaver * Taylor Woolwine *
|
Damon Mohl
Steve Paddack
CK Nichelson
|
central gallery
ONE 5 The $1500 award goes to: ABOUT THE MANIFEST PRIZE: All of Manifest's calls for entry are competitive. The stiffness of the competition has increased in proportion to Manifest's growing reputation, multi-faceted mission, and international reach. Our mission to stand for quality, to create a system whereby works are judged with objectivity as a primary aim, and assembled with as little subjective curatorial agenda as possible has gained the respect of thousands of artists from all over the world, and a vast following of arts lovers, patrons, and supporters. We respect the creative principle of reduction (the jury process) as it is employed to achieve an essential conclusive statement for each exhibit we produce. This is what has led to the high caliber of each Manifest exhibit, and to the gallery's notable reputation. We believe ompetition does breed excellence. With this principle of reduction in mind, we have been inspired by the intensity of jury after jury to narrow down a collection of entries to a strong end result. Therefore we determined five years ago to launch the Manifest Prize in order to push the process to the ultimate limit—from among many to select just ONE work. Manifest's jury process for ONE 5 included multiple levels of jury review of 487 works by 163 artists by a total of 18 different jurors. Each level resulted in fewer works passing on to the next, until a winner was reached. The size and physical nature of the works considered was not a factor in the jury scoring and selection. The winning work is entitled "Precipitous" by Nicole Pietrantoni of Walla Walla, Washington. It will is the recipient of the 5th annual MANIFEST PRIZE, and will be presented in the Central Gallery from December 12 through January 9, 2015. It will be accompanied by several juror statements and the artist's statement. About the artist: Nicole Pietrantoni’s artwork explores the complex relationship between human beings and nature via installations, artists’ books, and works on paper. She is the recipient of numerous grants and awards including a Fulbright to Iceland, a Leifur Eiríksson Foundation Grant, the Larry Sommers Printmaking Fellowship, and the Elizabeth Catlett Fellowship. Nicole has been awarded artist residencies at the Anderson Ranch Arts Center and the SIM RES in Reykjavik Iceland, among others. Her prints and installations have been featured in over 70 national, international, and traveling exhibitions, and are held in private and public collections around the world. Nicole received her MFA and MA in Printmaking at the University of Iowa and her BS in Art History and Human and Organizational Development at Vanderbilt University. She is currently an Assistant Professor of Art at Whitman College in Walla Walla, Washington, where she teaches printmaking and book arts.
The Manifest Prize is an annual international competition. With increased sponsorship the prize amount may be increased to $5,000 for ONE 6. Five semi-finalists will also be featured in the season-documenting Manifest Exhibition Annual publication (MEAs11). These are works by Ryan Buyssens (Orlando, Florida), Jesse Berlin (Tucson, Arizona), Patricia Bellan-Gillen (Burgettstown, Pennsylvania), Joomi Chung (Oxford, Ohio), and Adam Niklewicz (North Haven, Connecticut).
|
|
north gallery
LIMINAL
This solo exhibition of six of Robert Kolomyski's paintings is one of eleven selected from among 199 proposals submitted for consideration for Manifest's current season. Robert Kolomyski's large, engulfing paintings do exactly what he says they are meant to—balance the edge between the idea and the physical, notion and substance. At the same time, while remaining coyly untitled, they suggest strong references to art historical paintings, baroque or otherewise—things we're sure we've seen before but discern now only in a half-state. They leave us feeling perhaps as if we share in this liminal circumstance, meeting the work half-way somewhere in a gallery, someplace in time. Their power and scale will energize Manifest's North Gallery and beam a vibrancy through the window, across the sidewalk, and onto Woodburn Avenue. Passersby will not be able to refuse their insistence.
Of his work Kolomyski states: "I am interested in engaging the language of modernist painting, specifically gesture and materiality, with the contemporary collage space. I hope to convey the sense of tension and uncertainty of this transitional stage of painting's history, where unity and variety bump heads in poetic jumbles of image, mark and surface. This particular group of paintings will explore the slippage of the material into the virtual. When does such a bodily thing such as paint, a thing so much like us in the world in its range of surfaces and temperaments, become a thing of the mind, an image, a memory? And conversely, what is the point at which something as virtual as a feeling or notion body itself into the world? My work explores these slippages between states of being, seeking out a liminal state between category and cacophony." Robert James Kolomyski is a Professor of Painting and Drawing at Inver Hills College in St. Paul, MN. He received an MFA in painting in 2007 from Michigan State University. Over the last several years, Robert has shown at several national and international galleries and museums including the Soo Visual Arts Center, in Minneapolis, MN, the Brownsville Museum of Fine Arts, TX, the Kuandu Museum of Fine Arts in Taipei, Taiwan, the Da Xiang Art Space in Taichung City, Taiwan, Ever Gold Gallery in San Francisco, CA, The Lexington Art League in Lexington, KY, The Foundry Art Center in St. Louis, MO and Max Fish Gallery in New York City, NY. Kolomyski's work has also been selected for inclusion in several major publications including the Manifest's own International Painting Annual, Weak Painting (Exhibition Catalog), by Garden City Publishing Taipei, Taiwan, What is Weak Painting?, Review by Tzu-Chieh, Jian, Garden City Publishing, Taipei, Taiwan, and Studio Visit Volume 8, by The Open Studio Press Boston, MA. A polymorph of everyday fragments and painting's grand tradition, Kolomyski's work achieves hard-won images of timeless and poetic worlds.
Kolomyski's work was last exhibited at Manifest in Fresh Paint during Season 10 and is also included in Manifest's International Painting Annuals 1, 3, and 4.
|
|
| January 23 - February 20 | Opening Reception - Friday, January 23, 6-9 p.m. |
main gallery + drawing room
SCIENTIFICOUS
Powerful or beautiful imagery often results from non-artistic processes. Likewise, works of art sometimes examine techniques or concepts by implementing scientific methods, or feature data originally resulting from science as subject matter. Throughout history art and science have been kindred outgrowths of human endeavor. While some may say they are polar opposites we propose that art and science simply occupy two ends of a continuum, across which a rich and vibrant dialogue of interaction and discovery can result. This can lead to unpredictable, truly remarkable, and humanly relevant results. With this in mind we offered this call to artists, scientists, and others for works that explore the idea of science resulting in artistic artifacts, as well as artwork that employs or is generated by a scientific process. All manner of interpretations of this theme were welcome. Manifest's several-member blind jury process reviewed 360 works by 120 artists from 31 states and 9 countries. Twenty-five works by the following 20 artists from 13 states and 4 countries including Norway, England, Canada, and the United States were selected for exhibition and will also be featured in the Manifest Exhibition Annual publication (MEA) at the close of the season. Presenting works by: Victoria Fuller Juan Gomez-Perales Jay Gould Anders Gramer Brandice Guerra William Haney Daniel Kariko Kent Krugh Jean-Claude Lajeunie Matthew Lee Anna Lindemann Maria Mangano Kenneth Millington Joe Muench Mark Nystrom Kathleen Taylor Dorothea Van Camp Dave Wagner Mary Wagner Stig Weston
|
Anders Gramer
Anna Lindemann
Matthew Lee
Kathleen Taylor
|
parallel space
In the Body of the World
This solo exhibition of Bryan Christie's paintings is one of eleven selected from among 199 proposals submitted for consideration for Manifest's current season. In the Body of the World provides a visceral experience of abstract painterly form, conceptual reflection about the human body, and the merging of technical processes from antiquity to the modern day. Through thoughtful balance of concept and process Christie develops a powerful set of objects (and imagery) which we're proud to showcase at Manifest.
Of his work Christie states: "This exhibit explores the spectrum of human experience: from trauma to transcendence, from the concrete to the abstract. I believe that our lives start with trauma as we are brought into the world from the safety of our mother's womb. We eventually die, experiencing the loss of all that is dear to us. Yet transcendence and the experience of the sublime are rooted in this fleeting material existence. The divine is made evident through tangible and sensual experience; without our physical selves, we would not experience moments of wonder and the mysterious." Born and raised in New York City, Bryan Christie is an award- winning artist whose work has been exhibited internationally and featured in such publications as The New York Times, The New Yorker, TIME, WIRED, and Esquire. Bryan Christie's work is influenced by his unique background as a jazz musician, as an art director for Scientific American magazine, and as a child growing up around the turpentine and oil paints of his mother's art studio. His artwork investigates science's relationship to art—how the arts and sciences attempt to explain and give meaning to our world using logic, intuition, and emotion. His aesthetic focuses on the essential structures of the body and demonstrates awe in how it functions and is put together through nature's remarkable intelligence.
Christie's work was last exhibited at Manifest in Fresh Paint during Season 10 and will also included in Manifest's forthcoming International Painting Annual 5.
|
|
central gallery + north gallery
SCHISM
schism One might say life itself is a product of conflict. History is riven by it, as is our present-day society. Species vie, nations war, couples fight, ideologies clash—the list goes on. As a force of existence conflict is neutral, but as a force of humanity this is rarely the case. Results of conflict vary, from the horrendous to the miraculous, from destruction to creation. Nevertheless it is an integral part of any evolutionary process and therefore progress. With these thoughts in mind we offered this call to artists for works of art that involve the idea of conflict. Manifest's blind jury process reviewed 225 works by 93 artists from 28 states and 5 countries. Eight works by the following 7 artists from 7 states were selected for exhibition and will also be featured in the Manifest Exhibition Annual publication (MEA) at the close of the season. Presenting works by: Nathaniel Foley M Tobias Hall Melissa Hall David Hicks Blazo Kovacevic Steven Subotnick Michael Tole
|
Blazo Kovacevic
Steven Subotnick
David Hicks
|
| March 6 - April 3 | Opening Reception - Friday, March 6, 6-9 p.m. |
main gallery + drawing room
IN SITU
So often works of art are portable, providing a transferable context-independent experience. This is especially the case in a gallery like Manifest which exhibits works from broad national and international origins on a regular basis. However this fact tends to preclude the presentation of works made site-specific, either customized for installation in our galleries, created on-site, or otherwise contingent upon assembly, display, or experience in a particular place. So in an effort to expand our exhibition scope Manifest called for proposals for works that would be made in place. We reviewed 60 proposed works by 23 artists from 12 states. Two works by two artists, each devoted to its own gallery space, were selected for exhibition and will also be documented in the Manifest Exhibition Annual publication (MEA) at the close of the season. main gallery Eric Troffkin This work brings Troffkin's modular structures indoors through a surreal merging of a twisting communication tower-like structure and various semi-geometric pods. Juxtaposed into the context of our comparatively small gallery the work plays off the idea of the organic growth of technology, or perhaps mutation through forced cultivation. drawing room What I see is what you get, 2014 (Cincinnati), 2015 The work in the gallery will be generated using software that tracks the artist's gaze through the gallery space over time. The data will then be transferred into actual material, direction, intersections, and size changes and ultimately the shape of the work in space. The work fittingly brings a different perspective to the notion of drawing, time in art, and the gallery space as a place for art to happen.
|
Eric Troffkin
Ariel Brice
|
parallel space
REGIONAL SHOWCASE
In its first ten seasons Manifest's projects included works by artists in 50 states and 37 countries. Starting with its 10th season Manifest launched a new ongoing series of exhibits focusing on works by artists living in its own three-state region. Season 11 continues that series, and adds projects like this one, focusing on definable regions outside our own. Our Regional Showcases are intended to complement the ordinarily very wide geographical makeup of most Manifest exhibits with a closer look at what's being done in particular places. For this fifth in the series we opted to produce two exhibits to survey the states of Florida and Michigan (the north/south extremes of Interstate 75) through an open call for works of any kind. Manifest's several-member blind jury process reviewed 225 works by 74 artists in Michigan and Florida for this two-exhibit parallel regional survey. Twenty-two artists from Florida, and 52 artists from Michigan responded to the call. Seven works by the following 3 artists from Florida were selected for exhibition and will also be featured in the Manifest Exhibition Annual publication (MEA) at the close of the season. Presenting works by: Kevin Curry Omalix Julio Suarez
|
Kevin Curry
Omalix
Julio Suarez
|
central gallery
REGIONAL SHOWCASE
In its first ten seasons Manifest's projects included works by artists in 50 states and 37 countries. Starting with its 10th season Manifest launched a new ongoing series of exhibits focusing on works by artists living in its own three-state region. Season 11 continues that series, and adds projects like this one, focusing on definable regions outside our own. Our Regional Showcases are intended to complement the ordinarily very wide geographical makeup of most Manifest exhibits with a closer look at what's being done in particular places. For this fifth in the series we opted to produce two exhibits to survey the states of Florida and Michigan (the north/south extremes of Interstate 75) through an open call for works of any kind. Manifest's several-member blind jury process reviewed 225 works by 74 artists in Michigan and Florida for this two-exhibit parallel regional survey. Twenty-two artists from Florida, and 52 artists from Michigan responded to the call. Nine works by the following 8 artists from Michigan were selected for exhibition and will also be featured in the Manifest Exhibition Annual publication (MEA) at the close of the season.
Presenting works by: Collin Bradford Trevor King Clayton Lewis Louis Marinaro Taylor Mazer Kyle Miller Nick Reszetar Greg Stahly
|
Kyle Miller
Taylor Mazer
Trevor King
|
north gallery
Interstellar Public artist's talk: Saturday, March 21, 5pm This solo exhibition of Samantha Parker Salazar's work is one of eleven selected from among 199 proposals submitted for consideration for Manifest's current season. Interstellar provides a rare opportunity for an artist to use the gallery as the starting point for the creation of a work just for that space. Taking advantage of the intimacy of the North Gallery along with its 24/7 full-height exposure to Woodburn Avenue, the exhibit will explore how Manifest can remain in place, but still reach outwards into its immediate community, engaging and benefitting even those who are just passing by. We are proud to collaborate with Samantha, whose work of this nature is rapidly gaining recognition on an international level.
Of her work the artist states: "Referencing life cycles on both the macro and micro scale, maelstroms of cut paper personify the inevitability of raveling and unraveling, construction and deconstruction. The paper components form a physical manifestation of tumultuous mental spaces, brought to life by an obsessive layering of surface imagery, stylized motifs, and fragments of tension between melancholy and the sublime. Samantha Parker Salazar (b.1989) is currently the John Fergus Family Post-MFA Fellow and lecturer in the printmaking area at The Ohio State University. Salazar received her MFA from The University of Texas at Austin in 2014 and her BFA from Bradley University in 2011. She has exhibited and installed permanent projects at venues both nationally and internationally, and will be a resident artist at the Frans Masereel Centrum in Kasterlee, Belgium during Summer 2015.
|
|
| April 17 - May 15 | Opening Reception - Friday, April 17, 6-9 p.m. |
main gallery
BORDER CREATURES
Public artist's talk: Friday, May 15, 6pm This solo exhibition of Adrian Cox's work is one of eleven selected from among 199 proposals submitted for consideration in Manifest's current season. Border Creatures brings an entire ecosystem into Manifest's Main Gallery, populating it with Cox's recent surreal conceptions. Walking a delicate and therefore powerful line between narrative illustration, traditional figurative painting subjects, and expressionism, the mostly large works allude to much that has come before, yet they stand firmly on their own. This makes for what can only be considered a unique and impactful experience in the situation of an in-the-round gallery presentation. Of his work the artist states: My work weaves a narrative of transgressive embodiment and builds a mythos of the grotesque. The characters in these paintings obliterate the natural limits of the body; sensuous extensions and wound-like openings facilitate an intense connection to their environment. I call these figures Border Creatures, as they are defined by such shifting and indeterminate boundaries. Adrian Cox (born 1988) is a painter living and working in St. Louis, Missouri. His studio practice involves a continuing exploration of transgressive bodies in figurative painting. In his recent work, he seeks to create a mythology of the grotesque, representing the morphic body as a heroic and empathetic subject. Adrian currently works as an adjunct lecturer in painting in the Sam Fox School of Design & Visual Arts at Washington University in Saint Louis.
|
|
drawing room
A VIEW OF NOWHERE
Public artist's talk: Friday, May 15, 6pm This solo exhibition of Cincinnati-based artist Philip LaVelle's work is one of eleven selected from among 199 proposals submitted for consideration for Manifest's current season. A View of Nowhere offers an intimate experience of LaVelle's paintings in various sizes, from large to quite small. The works pair the artist's conceptual interests with excellently applied formal design, resulting in both a highly engaging aesthetic and intellectual gallery experience. Of his work the artist states: How do we begin to comprehend the infinite landscape of the virtual? It is an exponential reality that we move through with a seemingly irrational ease. We use technology to annex knowledge that we recount with speed that would have been unfathomable even in the recent past. With the use of personal devices that act as portals we are able to live in two worlds simultaneously. These mechanical extensions are so “natural” that when we do not have them it feels as if we are lacking one of our senses. We use this world to store and consume information, however, we are ghosts: ’we have no bodies'. In the past few years I have developed work that explores our world and our simultaneous experiences split between the 'real' and the 'virtual'.These experiences have grown at an expansional rate as our technology both acts as a vehicle that binds us though virtual connection and the ability to annex our brain and yet creates a displacement in our physical lives. I use painting, a nonlinear yet simultaneously experienced medium to create an abstract interpretation of our contemporary “landscape” or a more appropriately termed “visual scape”. The works, although created intuitively and mostly by hand, both reference and use commercial, mechanical and digital production, both in aesthetic and process. By compressing many layers together I reference the simultaneousness of the virtual and look at creating works that are nonlinear abstractions of our everyday interactions with both the material and immaterial world. I use abstraction and image to create something both familiar and foreign. I attempt to create paintings of “a place without space and the worlds in between”. Philip LaVelle is an award-winning Cincinnati-based artist who graduated Summa Cum Laude with a BFA in Painting and with Departmental Honors in Art History with a focus in Contemporary Theory from Ohio University. In the past few years he has been working on a series of works that use the language and process of painting, photography, and commercial design to explore ideas of our contemporary “landscape” that exists both in the “real” and the “virtual”. The simultaneous nature of these worlds forms a visual schizophrenia where information begins to fold in on itself. These invisible landscapes are rendered by layering nonsensical structures that play with depth and create shifting perspectives while referencing the virtual and place it within a schism of the material in a frozen flux.
|
|
parallel space + central gallery + north gallery
DRAWN
Manifest was founded in-part to stand for the importance of drawing as a process, skill, and discipline, and as a continuing viable product of the creative fine art and design fields. Since its inception the organization has continued to incorporate drawing-based programming, including education (Drawing Center), publications (INDA), and gallery exhibits into the broader spectrum of its projects. The students and professors who formed Manifest in 2004 knew that despite their diverging career paths (architecture, art history, painting, industrial design, photography) they were brought together on account of their connection to drawing and their mutually intense but multi-faceted pursuit of this fundamental discipline. A year ago, in honor of the original spirit of the founding ideals of Manifest, the gallery launched DRAWN as a new annual exhibition. DRAWN seeks to survey and present the broad scope of drawing being made today. This gallery exhibit is completely separate from but nevertheless complements, and sometimes overlaps, the annual INDA publication project. DRAWN called for artists to submit works of drawing in any media relevant to the practice (including non-traditional approaches), any style, and any genre (fine art, illustration, design, conceptual, realism, etc.). For this exhibit 394 artists from 44 states, 20 countries, and Washington D.C. submitted 1188 works for consideration. Thirty-six works by the following 27 artists from 13 states, England, Japan, and Spain were selected for presentation in the gallery and Manifest Exhibition Annual publication. Presenting works by: Lindsey Aleman Kelly Borsheim Sue Bryan Katherine Cox Amir Hariri Daisie Hoitsma Margaret Hopkins Lori Johnson Patti Jordan Jean LeCluyse Tim Main Free Marseille Darren Marsh Ryota Matsumoto Taylor Mazer Zach Mory Jack Nixon Adam Rake Susan Rotondo Mariasun Salgado Amy Schissel John Spurlock Geoffrey Stein Kirsten Stolle Amber Stucke Derek Wilkinson Christine Wuenschel
|
Jack Nixon
Mariasun Salgado
Darren Marsh
Patti Jordan
Geoffrey Stein
|
| May 29 – June 26 | Opening Reception - Friday, May 29, 6-9 p.m. |
main gallery
RITES OF PASSAGE An Exhibit of Works by Current or Recent Undergraduates Initiated in 2005, The Rites of Passage exhibits were developed to support student excellence by offering a public venue for the display of advanced creative research; to promote young artists as they transition into their professional careers; and to bring the positive creative energies of regional and national institutions together in one place. With this eleventh annual installment of the Rites series, Manifest offers a $500 best of show award to reward excellence at this career level. The Rites call for submissions was open to students graduating or expecting to graduate in 2014, 2015, or 2016 (undergraduate juniors, seniors, and those who graduated last year). For this exhibit 87 artists representing 62 academic institutions submitted 275 works for consideration. Thirteen works by the following 11 artists representing ten different academic institutions are featured in the 11th annual Rites of Passage exhibit. Artists are listed with their academic status as of the dates of their entry into this competition. Why is this important?
Martha Gaustad Shelby Huber Todd Kunkler Daniel Lauterbach Cristina Marquez Ryan Meyer Samantha Slone Madeline Rile Smith Toan Vuong Jeremy Walbridge Grant Wells
|
Martha Gaustad, Senior, Bowling Green University
Madeline Rile Smith, 2014 Graduate, Tyler School of Art
Ryan Meyer, 2014 Graduate, University of Alabama
Todd Kunkler, Senior, Ohio University
|
drawing room + parallel space
MAGNITUDE SEVEN Back in 2005 we launched the Magnitude Seven project with the idea that small works would be easier and more practical for artists to send to Manifest from anywhere in the world. This proved true, and right off it was this project that lead to Manifest gaining the tag line 'a neighborhood gallery for the world.' This iteration of the exhibit is no different, with works coming together from California, Indiana, Texas, Kansas, Kentucky, Michigan, Mississippi, Missouri, Nebraska, New York, Ohio, Oregon, Tennessee, and the countries of France and the Netherlands.. Inevitably MAG 7 is a melange of various works, including an extremely wide range of media, styles, and artist intents.The exhibit always gains unity from the common scale, so even disparate works seem to engage in playful and tolerant conversation across the gallery or side by side. We have found that having a couple galleries full of hand-sized works is somehow a relief steeped in the joy of small things well made, a menagerie of creativity, and a poignant reminder that bigger is not always better. We are happy to offer this eleventh annual exhibit of works no larger than seven inches in any dimension. For this year's project 198 artists from 39 states and 10 countries submitted 540 works for consideration by Manifest's intensely competitive jury process. Twenty-three works by the following 19 artists from 13 states and 3 countries were selected for presentation in the gallery and the new season-documenting Manifest Exhibition Annual.
Travis Michael Bailey Anna Belleforte Logan Blanco Susan Bryant Michael Van Buskirk Neil Callander Derek Courtney Marion Delarue John Ferry Tanja Gant Mark Langeneckert Taylor Mazer Vince Natale Caroline Owen Nick Reszetar Alicia Rothman Christian Schmit Jenny Schoensiegel Walter Zurko
|
Nick Reszetar
Vince Natale
Travis Michael Bailey
Christian Schmit
|
central gallery + north gallery
MAR 2014/15 Artists' Gallery Talk: Saturday, June 20, 5pm The year-long Manifest Artist Residency was launched in 2012 with the goal to provide artists with a combination of free studio space, supportive resources such as teaching opportunities and free access to life drawing and other programs at the Manifest Drawing Center, the powerful creative culture that permeats all Manifest programs, and routine engagement with the gallery-visiting public during each of our nine exhibit receptions each season. Last season, afforded by the increase in Manifest's exhibition spaces, we were able to add yet another benefit to the MAR program–the MAR Showcase exhibition. This double-solo exhibit features works made by our two 2014/15 Artists in Residence, Christina Weaver and Taylor Woolwine. This marks the culmination of their residency at Manifest which concludes in June, and serves as a celebration of their achievements, learning, and heartfelt adoption into the broad Manifest 'family'.
ACCUMULATIONS ...A certain observational fidelity has always been essential to my work—an obligation to nail down the thing, a display of skill, an understanding of light, etc. Recreating different aspects of reality is one of my greatest joys as a painter. But over the past couple of years, I have found that what I am painting is no longer “just” still life, but dynamic landscapes or skyscapes, and occasionally something anatomical or something that suggests the presence or absence of the figure. So through cropping and lighting and paint handling, I have started playing up this unexpected and wonderful transcendence of my subjects. The work has become far more abstract. Though the imagery is still heavy with tangibility, I am learning to let go of the nameability of the things. By using my objects as vehicles or catalysts for paintings as opposed to final words, I have opened up a certain freedom for myself and have made room for invention and the further exploration of the formal elements of a painting—color, surface, shape. The paintings are beginning to stand alone apart from their subject matter, as opposed to existing solely as reiterations of reality.
UNRAVEL ...How does the artist capture a fleeting glimpse using a process that spans over many hours, days, or even weeks? I investigate this question through my paintings, which often consist of many layers of failed attempts to capture specific moments. Imbedded in nearly every painting are several views of the objects and interior of my studio. In this sense the paintings are tangible documented histories of their own making, as honest and open as possible. During the paintings’ construction, a steady stream of new imagery constantly intrudes on the old, creating jarring juxtapositions. The resulting images simultaneously contain everything and nothing, creating a new visual realm which transcends the sum of its parts.
|
Christina Weaver
Taylor Woolwine
|
| July 10 - August 7 | Opening Reception - Friday July 10, 6-9 p.m. |
main gallery + drawing room + parallel space +
9th Annual An Exhibit of Works by Current or Recent Graduate Students Building
upon the philosophy of the Rites
of Passage exhibits for undergrads, each year Manifest
offers a similar opportunity to current and recent graduate students
for exhibiting at Manifest. The exhibit is the only one to-date assigned to all five galleries at Manifest. As do our annual Rites of Passage and TAPPED exhibits, Master Pieces reflects our commitment to surveying, documenting, and presenting the state of arts in academia on an ongoing basis. We believe this is important to artists, the public, students, and professors. For this incarnation of the project 143 artists representing 74 different academic graduate programs submitted 466 works for consideration by Manifest's rigorous jury process. Nineteen works by the following 16 artists from 9 states representing 16 different academic programs were selected for presentation in the gallery and publication.
Stephanie J Baugh Don Burton Mike Callaghan Sara Catapano Matthew Deibel Lydia Dildilian John Engelman Zoey Frank Daisie Hoitsma Cecily Howell Soohyun Kim Erek Nass Toranj Noroozi Katrina Rattermann Tai Rogers Jeffrey Stenbom
|
Matthew Deibel
Zoey Frank
Soohyun Kim
Erek Nass
Jeffrey Stenbom
|
| August 14 – September 11, 2015 (SEASON 11 FINALÉ) | Opening Reception Friday August 14, 6-9 p.m. |
main gallery + drawing room
7th Annual NUDE
Manifest exhibits many kinds of works, from more conceptual and experimental art to the traditional. In fact we think it's important to have such a range in our repertoire. It is something that Manifest is known for. Our annual projects allow us the chance to track how artists around the world address a consistent theme, subject, or media over time, or allow us to document the state of art in a particular strata of professional creative activity, and to study and preserve our findings in a meaningful way through our publications and website. NUDE is one such project. The human body is a popular subject for many reasons, the most obvious being that it is us. Throughout history the representation of the human form has been charged with tremendous energy, both positive and negative. Whether it be a religious edict that one 'shalt not' depict the human form, a taboo, or the glorious opposite, a revelation of mastery over form in the crafting of sensuous and life-like physical human beauty, the art of the body has nevertheless moved us through time. Through all the permutations art has experienced across history, work of the body persists. We use the human nude to master skill, understand ourselves, and push social and psychological buttons for the sake of expression (sensual, delicate, aggressive, and so on). We intend for Manifest's ongoing annual NUDE project to explore how our collective body is used today in art to achieve these goals and more. This year we were excited to renew our invitation to artists to submit works in any media, of any style or genre (abstract, conceptual, highly realistic, etc.), and of any size and media, for consideration in Manifest's seventh annual NUDE, an international competitive exhibit exploring the uncovered human form in current art.
Presenting works by: Debra Balchen Mike Binzer Sally Bousquet Michael Durando Lucas James Barbara Kacicek William Kitchens Daniel Maidman Susannah Martin Marcus Michels Dora Natella Nick Reszetar Nadine Robbins Debra Small
|
Lucas James
Dora Natella
Nadine Robbins
|
parallel space
EXPATRIATES
In 10 seasons Manifest's projects have included works by artists in 50 states and 40 countries. Beginning last year, in its tenth season, Manifest launched a new ongoing series of exhibits focusing on works by artists in its own three-state region. This year we added projects that also focus on other definable regions outside our own. All of our Regional Showcases are intended to complement the ordinarily very wide geographical makeup of most Manifest exhibits with a closer look at what's being done here, now, in our own backyard. They also provide a platform from which we can examine the trends, qualities, and idiosyncrasies of contemporary art within specific geographical areas and compare them to our own. For our second exhibit showcasing works from other regions we decided to call for works made by artists who are originally from Ohio, Kentucky, or Indiana, but who no longer live in these three states. We had no predefined expectation for type or style of work to be considered or selected. More about the Regional Showcase Series: Manifest was founded, and continues to be operated by regional artists, so it is only fitting that the organization offers the Regional Showcase series. We feel this is important for the artists and the public living within reasonable driving distance of the gallery. It will give each a chance to show and share, and to gain perspective on our region's creative wealth as it relates to the broader art world. In cases where projects feature other regions it will serve to inform our local artists about works made by their peers elsewhere, and promote those 'outside' regional artists to our regional arts patrons.
Presenting works by: Neil Callander Rebecca Drolen Mary Farrell Flannery O’Kafka Jonathan Swanz Michael Van Buskirk Dorothea Van Camp
|
Neil Callander
Rebecca Drolen
Jonathan Swanz
|
central gallery
JUDGMENT
This solo exhibition of six of Jon Sours' paintings is one of eleven selected from among 199 proposals submitted for consideration for Manifest's 11th season.
Of his work Sours states: "I paint figures but try to avoid literal depictions of people. A common theme in my work is the act of judgment or appraisal. Reference materials such as photographs, film stills or magazine clippings serve as a jumping off point. The details inherent in these materials are essential to making a convincing picture, but tend to be distorted or made inaccurate in my depiction.”
Jon spent his formative years in New York and Nebraska, where he received his BFA in 2006 at the University of Nebraska, Omaha. He has worked as a landscaper, film projectionist and obituary clerk, but currently works as an art handler and gallery curator in North Carolina. He considers painting his main preoccupation. Jon's work has been exhibited across the country, and extensively in North Carolina. He was awarded an Artist Residency at the Kimmel Harding Nelson Center in 2013, and has had work included in previous Manifest exhibits and publications, including the recently released 4th International Painting Annual.
|
|
north gallery
THE FALLEN
This exhibition of nine of Michael Reedy's drawings is one of eleven selected from among 199 proposals submitted for consideration for Manifest's 11th season.
Of his work Reedy states: "The human figure has been central in my paintings and drawings for the last twenty years. My most recent works explore themes of life, death, and the human condition. This renewed curiosity in the physical limits of the body, and its ultimate failing (both outwardly and inwardly), has been paired with my prior interests long rooted in depictions of the body that fall outside the canon of art history (medical imaging and cartooning). Here, the ongoing references to anatomical illustration, and its benign approach to depicting pain and death, and cartooning serve to both underscore the comedic tragedy of physical existence and the frailties that increasingly define our sense of self as we age. In each instance, the unsettling presence of the open body presents complex questions of gender, pleasure, pain, interpretation, and reception, and results in works infused with a sense of scientific aura, moral lesson, and morbid entertainment. Consequently, the viewer is seduced into disregarding the boundaries between interior and exterior, between looking and feeling, and between the real and the pictured body.”
Michael Reedy received his MFA in painting from Northern Illinois University in 2000 and his BFA from North Central College in 1996. His work has been included in over 100 national and international exhibitions and can be viewed in numerous private and institutional collections, including Clatsop Community College, Minot State University, Shippensburg University, and the Hoffman Trust National Collection in association with the San Diego Art Institute.
|
|
——— END OF SEASON 11 ———
Manifest is supported by sustainability funding from
the Ohio Arts Council, and through the generous direct contributions of hundreds of individual supporters and private foundations who care deeply about Manifest's mission for the visual arts. |
Contribute to our Annual Fund |
|
|
Copyright © 2025 |

__032.jpg)
__119.jpg)
__185.jpg)
__127.jpg)
__125.jpg)
__086.jpg)
.jpg)



.jpg)


__0816.jpg)
__0954.jpg)
__0694.jpg)
__0537.jpg)
__1037.jpg)
__083.jpg)
__226.jpg)
__176.jpg)
__135.jpg)
__376.jpg)
__328.jpg)
__022.jpg)
__406.jpg)



___112.jpg)
___145.jpg)
___200.jpg)
___263.jpg)
___360.jpg)











